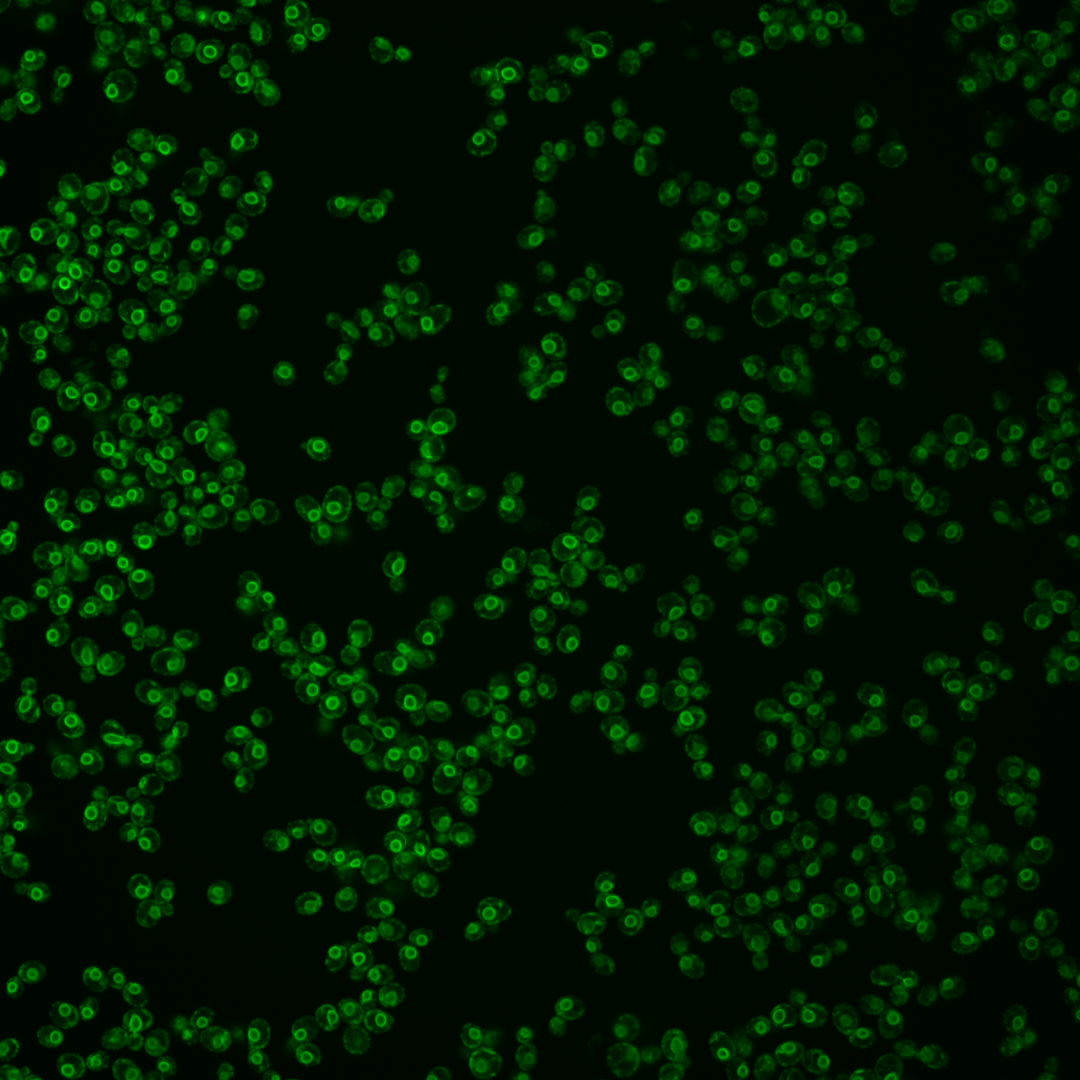
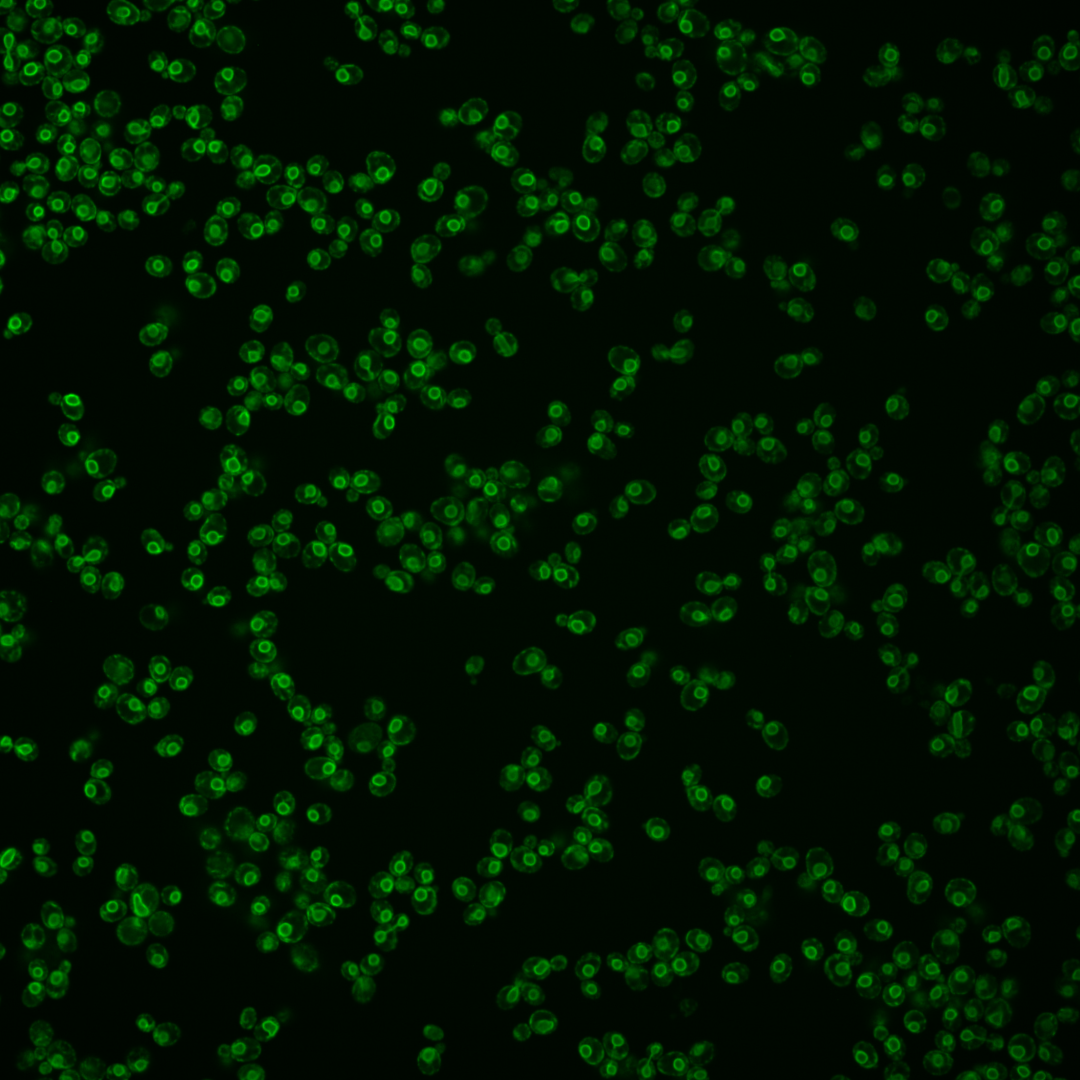
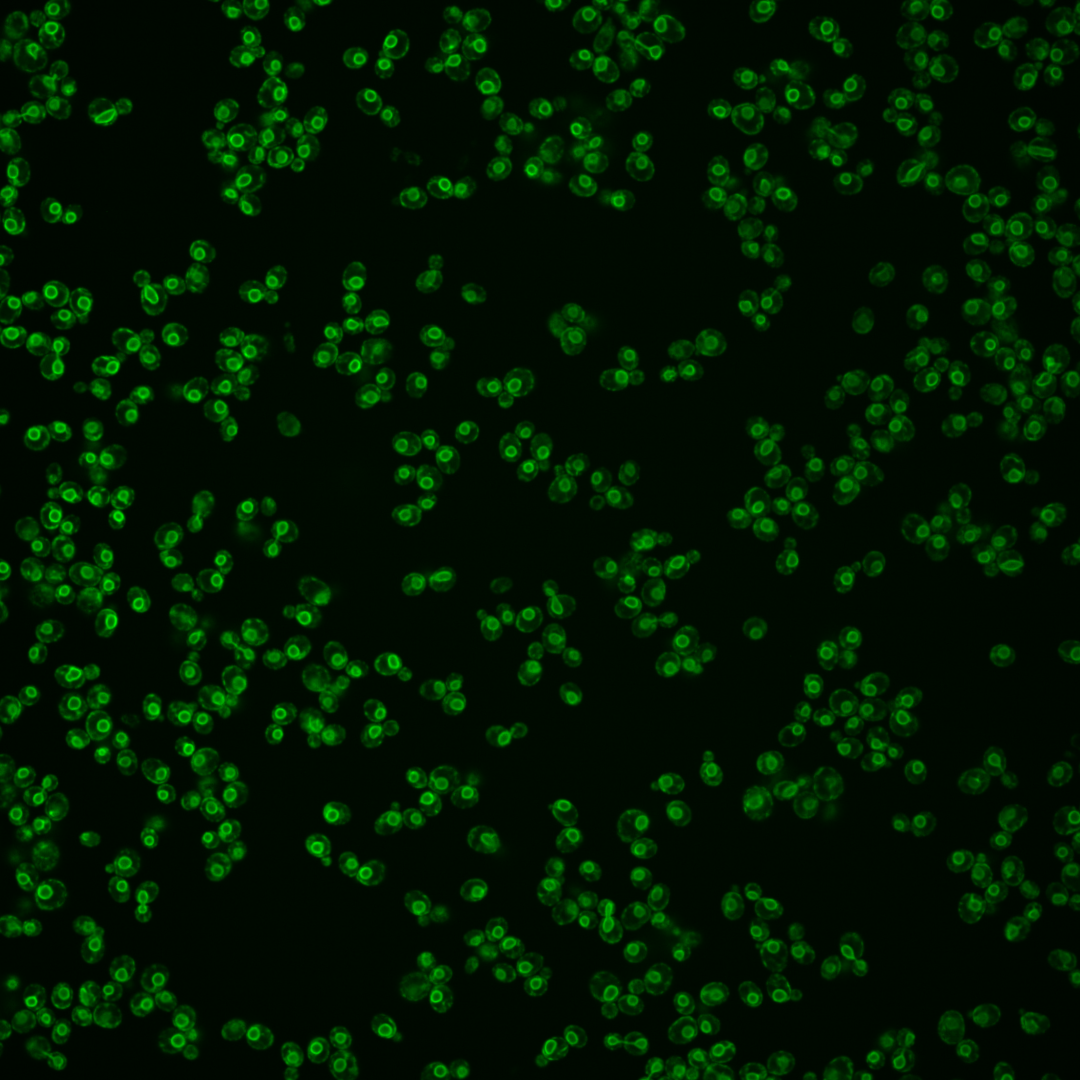
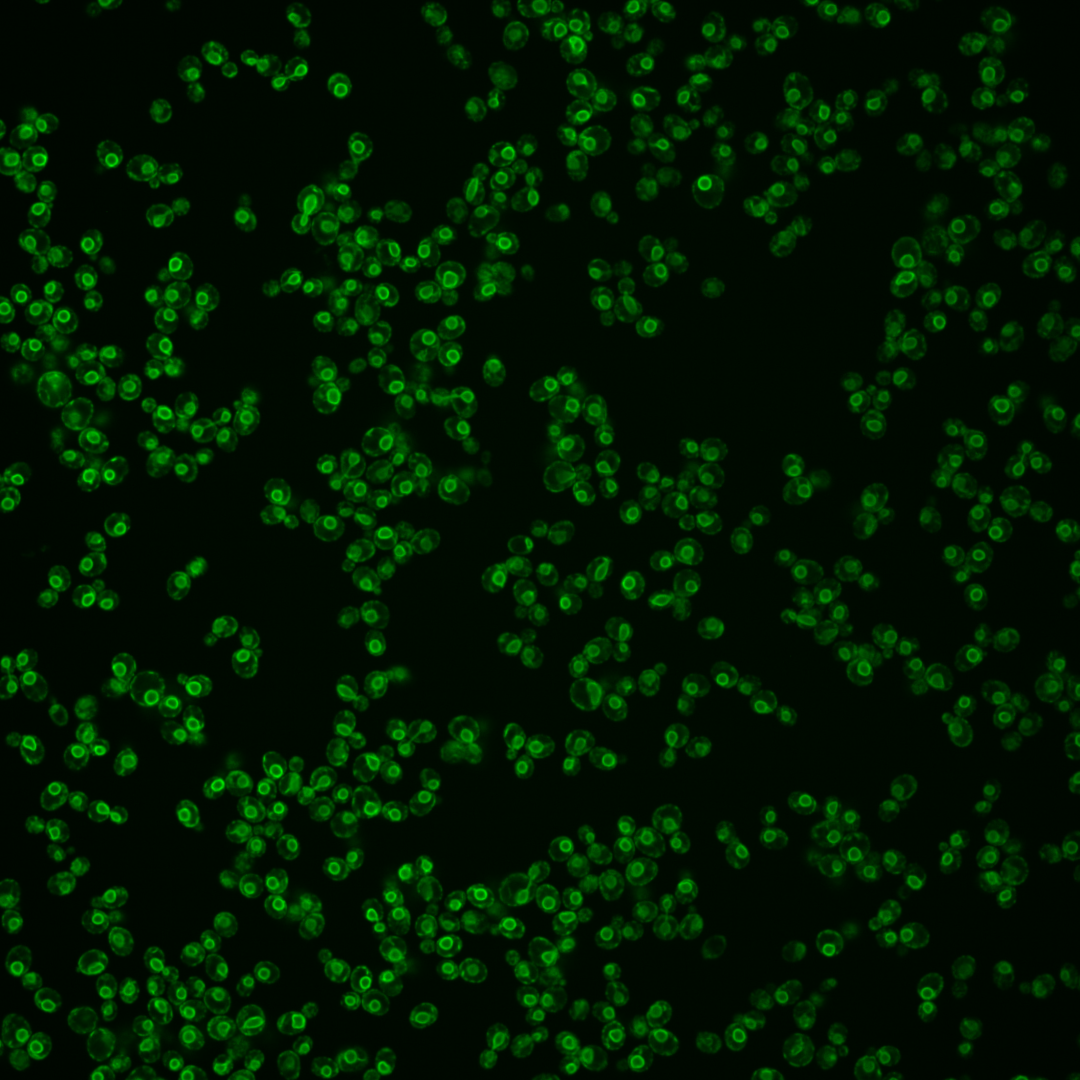
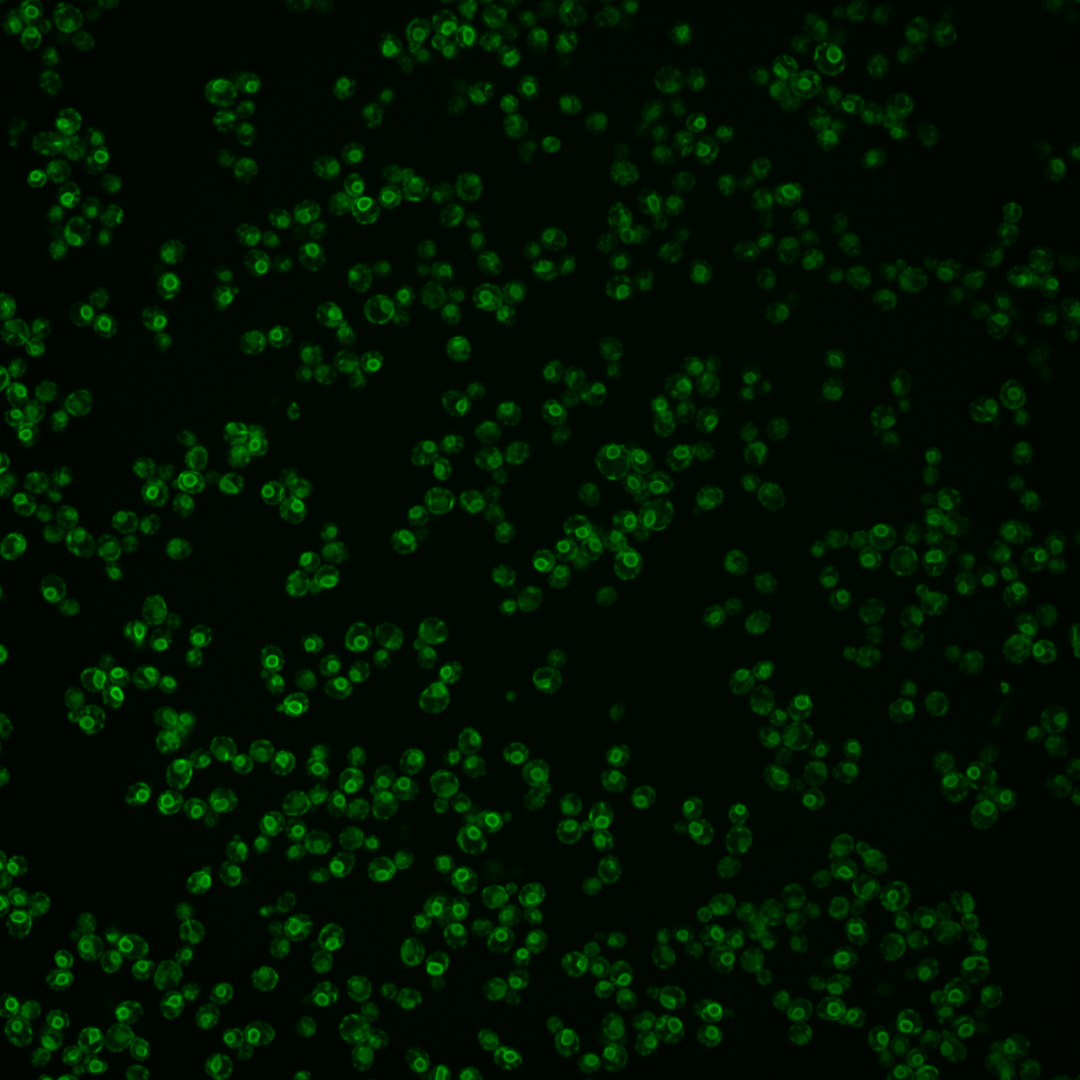
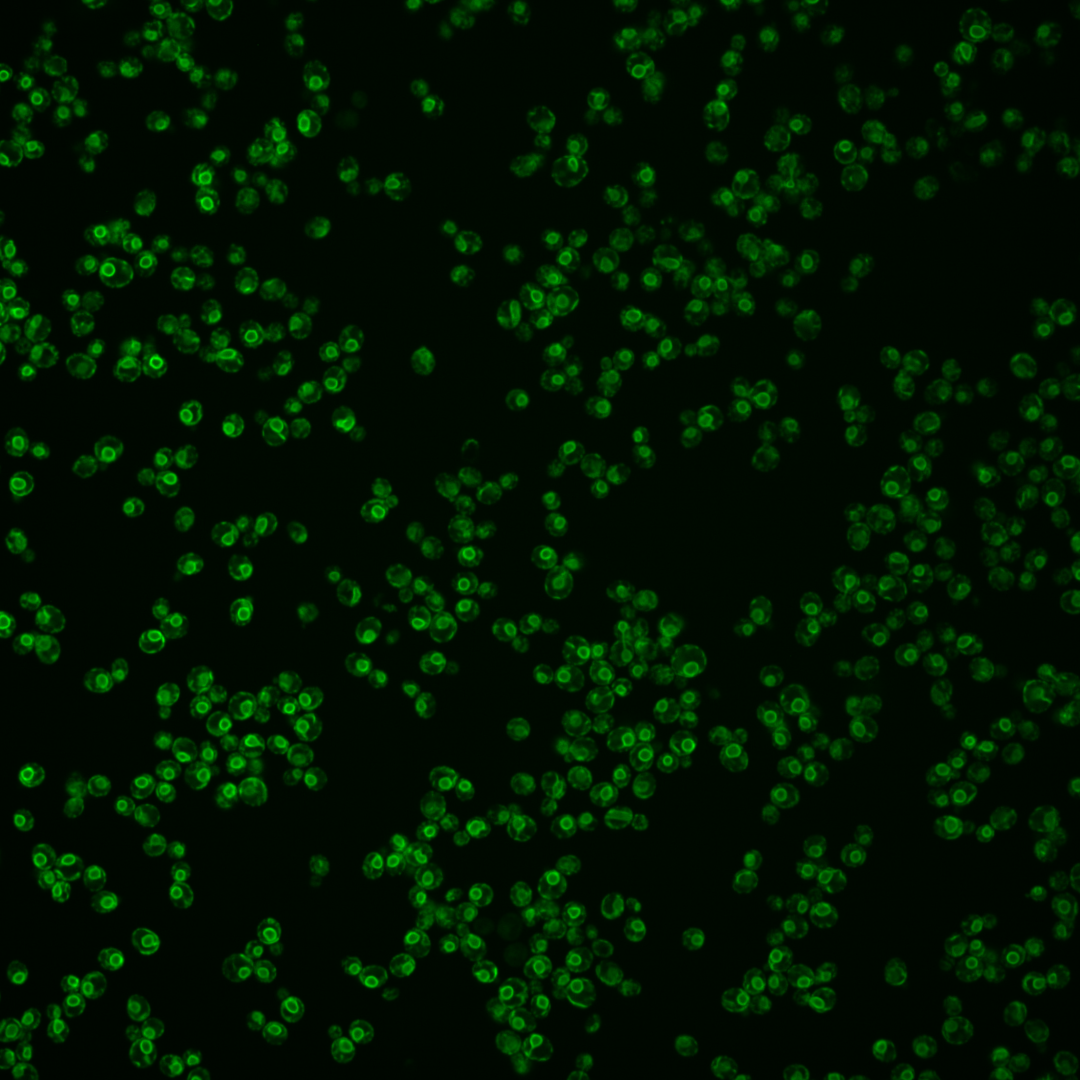
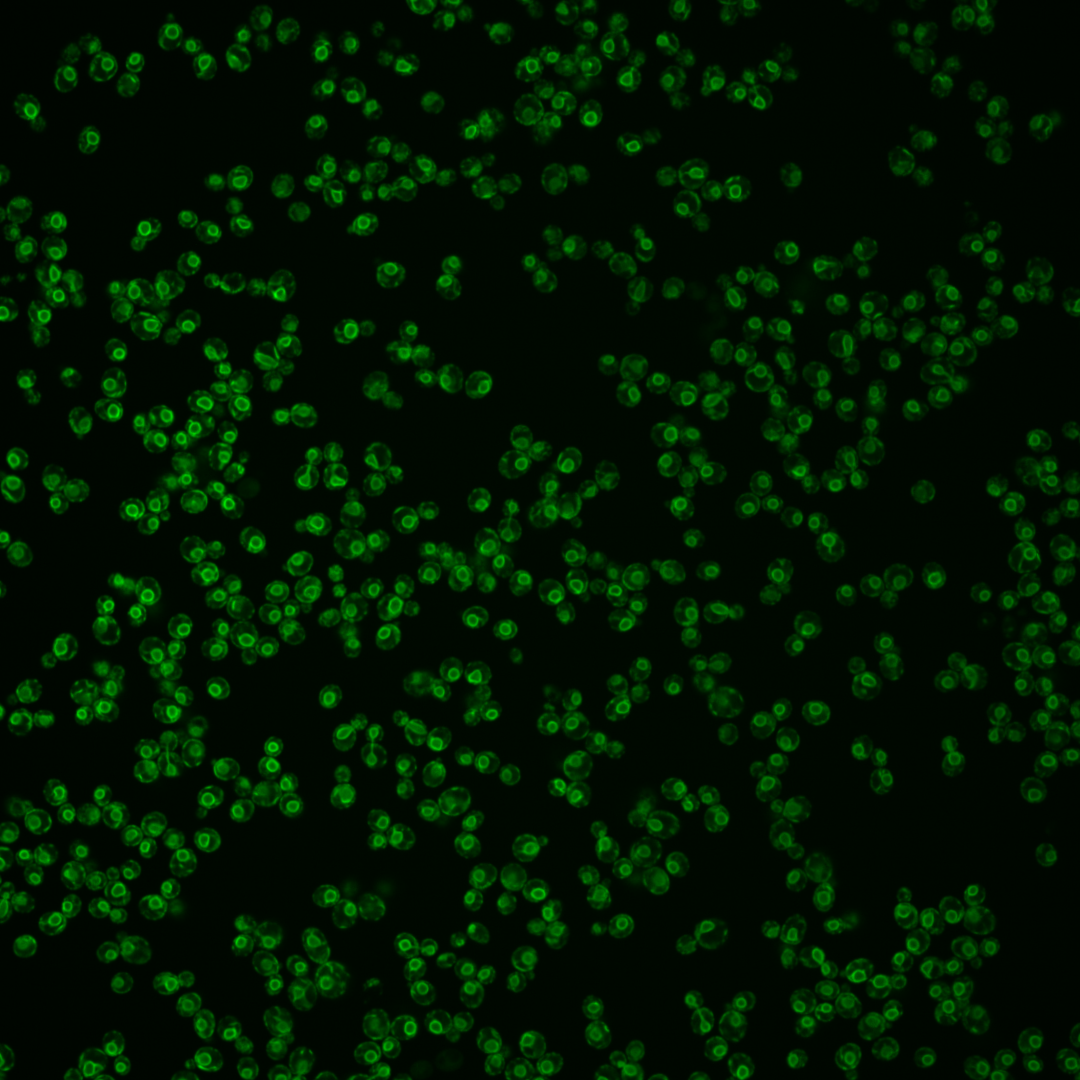

| Standard name | |
|---|---|
| Human Ortholog | |
| Description | Fatty acid elongase, involved in sphingolipid biosynthesis; acts on fatty acids of up to 24 carbons in length; mutations have regulatory effects on 1,3-beta-glucan synthase, vacuolar ATPase, and the secretory pathway; ELO2 has a paralog, ELO1, that arose from the whole genome duplication; lethality of the elo2 elo3 double null mutation is functionally complemented by human ELOVL1 and weakly complemented by human ELOVL3 or ELOV7 |
Micrographs




















































































Sub-cellular Localization
Yeast GFP Assignment
Protein Abundance
Localization Change
External localization resources
| ensLOC | DeepLoc | |||||||||||||||||||||||
|---|---|---|---|---|---|---|---|---|---|---|---|---|---|---|---|---|---|---|---|---|---|---|---|---|
| Localization | WT1 | WT2 | WT3 | RAP60 | RAP140 | RAP220 | RAP300 | RAP380 | RAP460 | RAP540 | RAP620 | RAP700 | HU80 | HU120 | HU160 | rpd3Δ_1 | rpd3Δ_2 | rpd3Δ_3 | WT1 | WT2 | WT3 | AF100 | AF140 | AF180 |
| Cortical Patches | 0 | 1 | 4 | 18 | 27 | 23 | 32 | 43 | – | 47 | 26 | 56 | 6 | 13 | 13 | 9 | 5 | 6 | 5 | 0 | 2 | 2 | 8 | 4 |
| Bud | 0 | 0 | 0 | 0 | 0 | 4 | 1 | 3 | – | 10 | 11 | 12 | 0 | 0 | 1 | 0 | 0 | 1 | 0 | 0 | 0 | 0 | 1 | 2 |
| Bud Neck | 0 | 0 | 0 | 0 | 0 | 0 | 0 | 0 | – | 0 | 0 | 0 | 0 | 0 | 0 | 0 | 0 | 0 | 0 | 0 | 0 | 0 | 0 | 0 |
| Bud Site | 0 | 0 | 0 | 0 | 0 | 0 | 0 | 0 | – | 0 | 0 | 0 | 0 | 0 | 0 | 0 | 0 | 0 | – | – | – | – | – | – |
| Cell Periphery | 12 | 5 | 5 | 3 | 11 | 9 | 17 | 20 | – | 32 | 26 | 32 | 11 | 32 | 49 | 36 | 25 | 20 | 0 | 0 | 0 | 1 | 0 | 1 |
| Cytoplasm | 5 | 8 | 9 | 12 | 32 | 41 | 43 | 47 | – | 49 | 57 | 64 | 7 | 13 | 11 | 28 | 23 | 18 | 0 | 1 | 1 | 2 | 2 | 3 |
| Endoplasmic Reticulum | 209 | 166 | 174 | 126 | 244 | 257 | 433 | 352 | – | 402 | 258 | 312 | 187 | 282 | 273 | 1 | 1 | 1 | 340 | 179 | 194 | 123 | 232 | 221 |
| Endosome | 0 | 0 | 0 | 0 | 0 | 1 | 0 | 0 | – | 1 | 0 | 3 | 0 | 0 | 0 | 1 | 0 | 0 | 0 | 1 | 0 | 1 | 0 | 0 |
| Golgi | 56 | 3 | 10 | 40 | 30 | 2 | 17 | 18 | – | 12 | 2 | 4 | 9 | 21 | 15 | 88 | 38 | 39 | 2 | 0 | 1 | 2 | 6 | 7 |
| Mitochondria | 0 | 1 | 0 | 5 | 14 | 33 | 56 | 47 | – | 50 | 102 | 151 | 0 | 0 | 0 | 15 | 10 | 6 | 3 | 0 | 1 | 0 | 5 | 2 |
| Nucleus | 1 | 0 | 0 | 0 | 0 | 4 | 2 | 3 | – | 1 | 2 | 0 | 0 | 0 | 0 | 1 | 1 | 2 | 0 | 0 | 0 | 0 | 0 | 0 |
| Nuclear Periphery | 13 | 1 | 50 | 26 | 26 | 16 | 63 | 43 | – | 43 | 40 | 55 | 9 | 14 | 3 | 3 | 5 | 2 | 7 | 1 | 3 | 0 | 4 | 2 |
| Nucleolus | 1 | 0 | 0 | 0 | 2 | 1 | 1 | 3 | – | 5 | 0 | 1 | 0 | 0 | 0 | 0 | 0 | 0 | 0 | 0 | 0 | 0 | 0 | 0 |
| Peroxisomes | 0 | 0 | 0 | 0 | 0 | 0 | 0 | 0 | – | 0 | 0 | 0 | 0 | 0 | 0 | 0 | 0 | 0 | 0 | 0 | 0 | 0 | 1 | 0 |
| SpindlePole | 0 | 0 | 0 | 0 | 0 | 0 | 0 | 0 | – | 0 | 1 | 0 | 0 | 0 | 0 | 0 | 0 | 0 | 0 | 0 | 0 | 0 | 0 | 0 |
| Vac/Vac Membrane | 45 | 8 | 2 | 10 | 31 | 42 | 74 | 126 | – | 99 | 58 | 84 | 13 | 3 | 2 | 5 | 5 | 3 | 5 | 3 | 2 | 2 | 6 | 15 |
| Unique Cell Count | 288 | 180 | 189 | 179 | 325 | 365 | 599 | 568 | 605 | 467 | 601 | 216 | 315 | 305 | 167 | 104 | 88 | 371 | 190 | 210 | 139 | 272 | 268 | |
| Labelled Cell Count | 342 | 193 | 254 | 240 | 417 | 433 | 739 | 705 | 751 | 583 | 774 | 242 | 378 | 367 | 187 | 113 | 98 | 371 | 190 | 210 | 139 | 272 | 268 | |
Yeast GFP Assignment
Protein Abundance
| Screen | WT1 | WT2 | WT3 | RAP60 | RAP140 | RAP220 | RAP300 | RAP380 | RAP460 | RAP540 | RAP620 | RAP700 | HU80 | HU120 | HU160 | rpd3Δ_1 | rpd3Δ_2 | rpd3Δ_3 | AF100 | AF140 | AF180 |
|---|---|---|---|---|---|---|---|---|---|---|---|---|---|---|---|---|---|---|---|---|---|
| Mean Cell GFP Intensity (1e-4) | 45.5 | 44.3 | 25.3 | 24.9 | 21.0 | 16.4 | 15.3 | 14.9 | – | 13.7 | 11.9 | 12.0 | 35.5 | 35.9 | 34.2 | 38.9 | 39.3 | 38.6 | 39.5 | 39.4 | 39.2 |
| Std Deviation (1e-4) | 11.5 | 8.5 | 5.6 | 6.2 | 4.7 | 3.4 | 3.3 | 3.1 | – | 3.0 | 2.7 | 2.7 | 7.0 | 7.3 | 6.4 | 9.1 | 9.5 | 9.6 | 8.1 | 11.0 | 9.1 |
| Intensity Change (Log2) | – | – | – | -0.02 | -0.27 | -0.62 | -0.72 | -0.77 | – | -0.88 | -1.09 | -1.07 | 0.49 | 0.51 | 0.44 | 0.62 | 0.64 | 0.61 | 0.64 | 0.64 | 0.63 |
Localization Change
| Localization | RAP60 | RAP140 | RAP220 | RAP300 | RAP380 | RAP460 | RAP540 | RAP620 | RAP700 | HU80 | HU120 | HU160 | rpd3Δ_1 | rpd3Δ_2 | rpd3Δ_3 |
|---|---|---|---|---|---|---|---|---|---|---|---|---|---|---|---|
| Cortical Patches | 3.2 | 2.8 | 2.2 | 1.9 | 2.7 | – | 2.8 | 1.9 | 3.3 | 0 | 1.2 | 1.3 | 1.6 | 0 | 0 |
| Bud | 0 | 0 | 0 | 0 | 0 | – | 0 | 0 | 0 | 0 | 0 | 0 | 0 | 0 | 0 |
| Bud Neck | 0 | 0 | 0 | 0 | 0 | – | 0 | 0 | 0 | 0 | 0 | 0 | 0 | 0 | 0 |
| Bud Site | 0 | 0 | 0 | 0 | 0 | – | 0 | 0 | 0 | 0 | 0 | 0 | 0 | 0 | 0 |
| Cell Periphery | 0 | 0.5 | 0 | 0.1 | 0.6 | – | 1.5 | 1.6 | 1.5 | 1.3 | 3.1 | 4.6 | 5.6 | 5.8 | 5.4 |
| Cytoplasm | 0.8 | 2.1 | 2.5 | 1.2 | 1.6 | – | 1.5 | 2.9 | 2.4 | -0.8 | -0.3 | -0.6 | 3.7 | 4.6 | 4.1 |
| Endoplasmic Reticulum | -5.4 | -4.8 | -5.8 | -5.6 | -7.8 | – | -6.9 | -9.0 | -9.9 | -1.8 | -0.9 | -0.9 | -17.2 | -15.2 | -14.6 |
| Endosome | 0 | 0 | 0 | 0 | 0 | – | 0 | 0 | 0 | 0 | 0 | 0 | 0 | 0 | 0 |
| Golgi | 4.8 | 1.6 | 0 | -1.6 | -1.3 | – | -2.4 | 0 | 0 | -0.5 | 0.6 | -0.2 | 10.0 | 6.9 | 7.9 |
| Mitochondria | 0 | 2.9 | 4.3 | 4.4 | 4.1 | – | 4.1 | 7.0 | 7.7 | 0 | 0 | 0 | 4.2 | 0 | 0 |
| Nucleus | 0 | 0 | 0 | 0 | 0 | – | 0 | 0 | 0 | 0 | 0 | 0 | 0 | 0 | 0 |
| Nuclear Periphery | -2.8 | -5.7 | -7.6 | -5.5 | -6.9 | – | -7.2 | -6.0 | -6.1 | -6.3 | -7.2 | -8.9 | -6.5 | -4.5 | -4.8 |
| Nucleolus | 0 | 0 | 0 | 0 | 0 | – | 0 | 0 | 0 | 0 | 0 | 0 | 0 | 0 | 0 |
| Peroxisomes | 0 | 0 | 0 | 0 | 0 | – | 0 | 0 | 0 | 0 | 0 | 0 | 0 | 0 | 0 |
| SpindlePole | 0 | 0 | 0 | 0 | 0 | – | 0 | 0 | 0 | 0 | 0 | 0 | 0 | 0 | 0 |
| Vacuole | 2.4 | 3.8 | 4.3 | 4.6 | 6.7 | – | 5.5 | 4.6 | 5.0 | 2.6 | 0 | 0 | 0 | 0 | 0 |
External localization resources
Images






























Protein Concentration and Protein Localization Data
| R1 | R2 | R3 | ||||||||||||||||
|---|---|---|---|---|---|---|---|---|---|---|---|---|---|---|---|---|---|---|
| G1 Pre-START | G1 Post-START | S/G2 | Metaphase | Anaphase | Telophase | G1 Pre-START | G1 Post-START | S/G2 | Metaphase | Anaphase | Telophase | G1 Pre-START | G1 Post-START | S/G2 | Metaphase | Anaphase | Telophase | |
| Concentration | 29.5099 | 31.0632 | 32.4347 | 31.3991 | 27.1744 | 32.0477 | 32.2277 | 35.2529 | 33.7784 | 30.3407 | 31.1972 | 34.3377 | 35.9884 | 32.9853 | 36.498 | 34.6155 | 32.2418 | 33.3491 |
| Actin | 0.0122 | 0.001 | 0.0014 | 0.0001 | 0.0182 | 0.0003 | 0.0148 | 0.0003 | 0.0155 | 0.0018 | 0.0036 | 0.0001 | 0.0019 | 0.0002 | 0.0001 | 0 | 0.0298 | 0.0017 |
| Bud | 0.0003 | 0 | 0.0002 | 0 | 0.0003 | 0 | 0.0003 | 0 | 0.0002 | 0.0001 | 0 | 0 | 0.0003 | 0 | 0 | 0 | 0.0001 | 0 |
| Bud Neck | 0.0004 | 0.0003 | 0.0002 | 0.0003 | 0.0006 | 0.0002 | 0.0003 | 0.0002 | 0.0007 | 0.0001 | 0.0002 | 0.0002 | 0.0002 | 0.0004 | 0.0002 | 0.0002 | 0.0005 | 0.0007 |
| Bud Periphery | 0.001 | 0.0001 | 0.0003 | 0 | 0.0003 | 0.0001 | 0.0005 | 0.0001 | 0.0002 | 0.0004 | 0.0001 | 0.0001 | 0.0004 | 0.0002 | 0 | 0 | 0.0004 | 0 |
| Bud Site | 0.0011 | 0.0004 | 0.0002 | 0 | 0.0006 | 0 | 0.0009 | 0 | 0.0015 | 0.0001 | 0.0001 | 0 | 0.0005 | 0.0001 | 0 | 0 | 0.0001 | 0 |
| Cell Periphery | 0.0033 | 0.0081 | 0.0054 | 0.0024 | 0.0011 | 0.0009 | 0.0055 | 0.0054 | 0.003 | 0.0042 | 0.004 | 0.0009 | 0.0045 | 0.0096 | 0.0042 | 0.0014 | 0.0068 | 0.0007 |
| Cytoplasm | 0.0302 | 0.0663 | 0.0161 | 0.0062 | 0.0017 | 0.0019 | 0.0025 | 0.0032 | 0.0036 | 0.002 | 0.001 | 0.0005 | 0.0042 | 0.0149 | 0.0052 | 0.0007 | 0.0014 | 0.0008 |
| Cytoplasmic Foci | 0.0236 | 0.0005 | 0.0109 | 0.0001 | 0.0398 | 0.0021 | 0.013 | 0.0002 | 0.0094 | 0.0016 | 0.0248 | 0 | 0.0015 | 0.0003 | 0 | 0 | 0.0008 | 0.0018 |
| Eisosomes | 0.0004 | 0.0002 | 0.0006 | 0.0001 | 0.0001 | 0 | 0.0007 | 0 | 0.0002 | 0.0007 | 0.0002 | 0 | 0.0005 | 0.0001 | 0 | 0.0001 | 0.0006 | 0 |
| Endoplasmic Reticulum | 0.7099 | 0.8299 | 0.8941 | 0.9079 | 0.809 | 0.8855 | 0.6932 | 0.9335 | 0.9012 | 0.8158 | 0.8124 | 0.8501 | 0.7807 | 0.9041 | 0.9539 | 0.9832 | 0.867 | 0.8809 |
| Endosome | 0.0152 | 0.0007 | 0.0097 | 0.0022 | 0.019 | 0.0031 | 0.0143 | 0.0007 | 0.0024 | 0.0106 | 0.0045 | 0.0005 | 0.0041 | 0.001 | 0.0002 | 0.0003 | 0.002 | 0.0007 |
| Golgi | 0.0036 | 0.0003 | 0.0018 | 0.0003 | 0.0338 | 0.0012 | 0.0117 | 0.0005 | 0.0018 | 0.0105 | 0.0039 | 0.0004 | 0.001 | 0.0013 | 0.0002 | 0.0004 | 0.0017 | 0.0003 |
| Lipid Particles | 0.0058 | 0.0023 | 0.0103 | 0.0001 | 0.0154 | 0.01 | 0.0147 | 0.007 | 0.0056 | 0.0174 | 0.0346 | 0.0006 | 0.0036 | 0.0139 | 0.0005 | 0.0004 | 0.004 | 0.0006 |
| Mitochondria | 0.004 | 0.0003 | 0.0027 | 0.0001 | 0.01 | 0.0081 | 0.021 | 0.0001 | 0.0058 | 0.0389 | 0.0072 | 0.0001 | 0.003 | 0.0001 | 0 | 0 | 0.0084 | 0.0001 |
| None | 0.0062 | 0.0003 | 0.0015 | 0 | 0.0002 | 0.0005 | 0.0022 | 0 | 0.0091 | 0.0006 | 0.0005 | 0 | 0.0011 | 0.0001 | 0 | 0 | 0.0024 | 0.0035 |
| Nuclear Periphery | 0.1448 | 0.0626 | 0.0296 | 0.0687 | 0.0391 | 0.0747 | 0.1668 | 0.0427 | 0.031 | 0.0769 | 0.0531 | 0.1382 | 0.1709 | 0.0405 | 0.0305 | 0.0106 | 0.0479 | 0.1012 |
| Nucleolus | 0.001 | 0.0002 | 0.0003 | 0 | 0 | 0.0007 | 0.0007 | 0 | 0.0003 | 0.0002 | 0.0004 | 0 | 0.0006 | 0.0001 | 0 | 0 | 0.0024 | 0 |
| Nucleus | 0.0113 | 0.0127 | 0.0026 | 0.0084 | 0.0008 | 0.0031 | 0.0074 | 0.0007 | 0.0014 | 0.001 | 0.0011 | 0.0009 | 0.0071 | 0.0028 | 0.0012 | 0.0002 | 0.0027 | 0.0018 |
| Peroxisomes | 0.0029 | 0 | 0.0016 | 0 | 0.0028 | 0.0004 | 0.0047 | 0 | 0.0018 | 0.0003 | 0.0306 | 0 | 0.0001 | 0 | 0 | 0 | 0.0013 | 0.0006 |
| Punctate Nuclear | 0.0033 | 0.0006 | 0.0008 | 0 | 0.0006 | 0.0002 | 0.009 | 0.0001 | 0.001 | 0.0001 | 0.0008 | 0 | 0.0011 | 0.0001 | 0 | 0 | 0.0009 | 0.0006 |
| Vacuole | 0.0103 | 0.0124 | 0.0077 | 0.0022 | 0.0049 | 0.0046 | 0.0065 | 0.004 | 0.0028 | 0.0079 | 0.0071 | 0.0035 | 0.0069 | 0.0092 | 0.003 | 0.002 | 0.0117 | 0.0017 |
| Vacuole Periphery | 0.0092 | 0.0007 | 0.0021 | 0.0007 | 0.0016 | 0.0023 | 0.0093 | 0.0012 | 0.0016 | 0.0086 | 0.0097 | 0.004 | 0.006 | 0.001 | 0.0007 | 0.0004 | 0.0069 | 0.0022 |
Sequencing Data
| R1 | R2 | |||||||||
|---|---|---|---|---|---|---|---|---|---|---|
| G1 Post-START | S/G2 | Metaphase | Anaphase | Telophase | G1 Post-START | S/G2 | Metaphase | Anaphase | Telophase | |
| Gene Expression | 172.2748 | 132.2727 | 112.1737 | 154.204 | 168.5491 | 100.35 | 136.3678 | 119.9248 | 88.0099 | 176.4932 |
| Translational Efficiency | 1.2463 | 1.6145 | 1.5533 | 0.8056 | 1.1085 | 2.0816 | 1.4205 | 1.1684 | 1.5095 | 1.1662 |
Hit Data
| Dataset | Hit |
|---|---|
| Protein Concentration | ✘ |
| Protein Localization | ✘ |
| Gene Expression | ✘ |
| Translational Efficiency | ✘ |
Endocytosis
| Temp | Actin Patch (Sac6-tdTomato) | Cortical Patch (Sla1-GFP) | Late Endosome (Snf7-GFP) | Vacuole (Vph1-GFP) |
|---|---|---|---|---|
| 37℃ | ||||
| RT |
Cell Cycle Omics
CYCLoPs (Elo2-GFP)
| Gene / Allele | Actin Patch (Sac6-tdTomato) | Cortical Patch (Sla1-GFP) | Late Endosome (Snf7-GFP) | Vacuole (Sac6-tdTomato) |
|---|
| Gene | Images |
|---|
| Gene | Images |
|---|
Images are not yet available
Images are not yet available